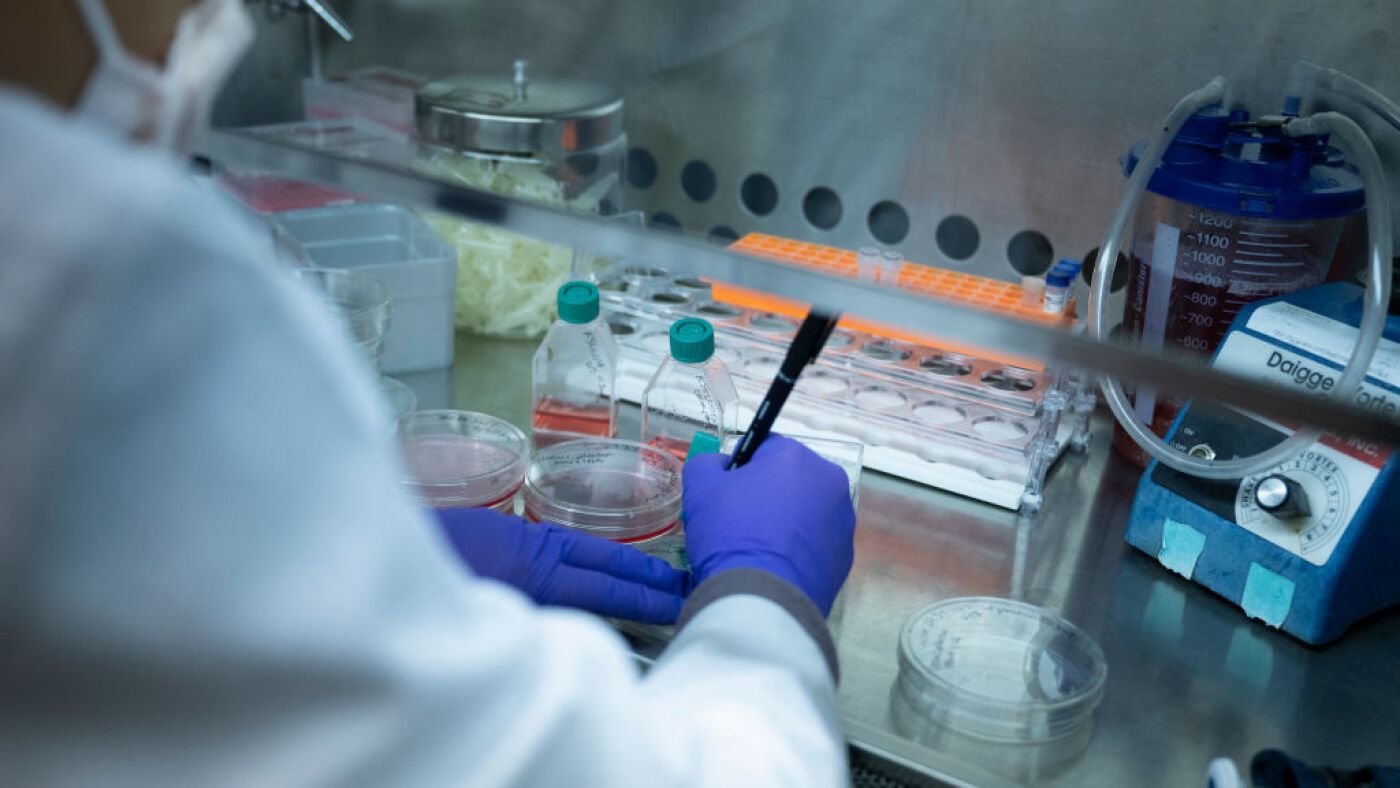
NIH proclaims new funding coverage that rattles medical researchers : Pictures NIH proclaims new funding coverage that rattles medical researchers : Pictures

4 yoga poses for sore runners
After a troublesome coaching block, your physique could really feel a bit beat up, even if you happen to’re mastering fuelling, your foam curler is your BFF and also you’re taking applicable restoration days. Whenever you’re stiff and sore, stretching and mobility work can really feel like a monumental chore. Enter these 4 easy yoga […]
4 yoga poses for sore runners Read More »

:max_bytes(150000):strip_icc()/GettyImages-1356363238-1721fd15cd0a4eebb66d3feccfee9956.jpg?w=1024&resize=1024,1024&ssl=1)